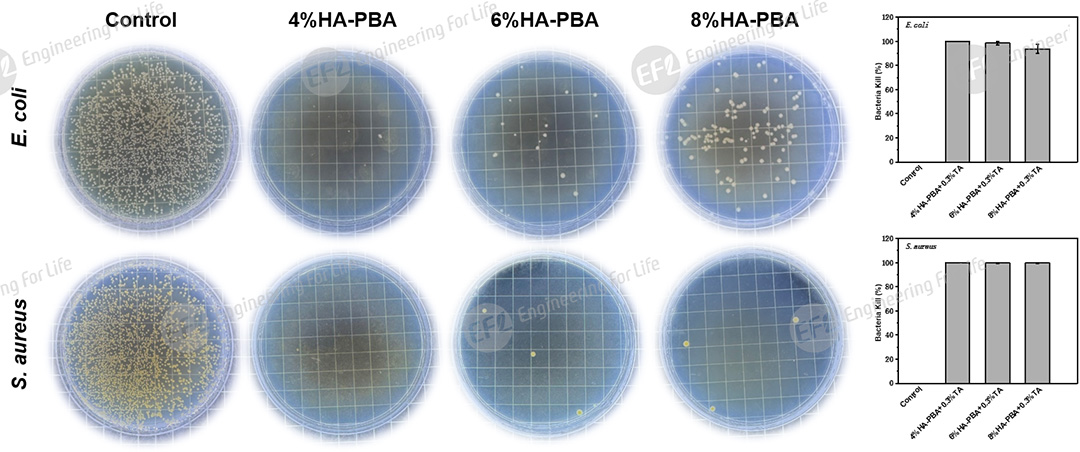
图片7.jpg

Tel: 0512-66958483
Email: engforlife-mkt@efl-tech.com

苯硼酸修饰透明质酸(HA-PBA);Phenylboronic Acid Modified Hyaluronic acid;
EFL-HA-PBA002
应用于组织再生、伤口敷料、响应释药等。
本品仅限于科研用途,请勿用于人体。
地区:北京+湖北
商务:陈婷
联系电话:15370307033(微信同号)
地区:上海+河北+河南+福建
商务:娟娟
联系电话:19951032231(微信同号)
地区:江苏+江西+湖南+重庆
商务:飞飞
联系电话:15365358233(微信同号)
地区:浙江+天津+辽宁+吉林+黑龙江
商务:立立
联系电话:15358847978(微信同号)
地区:山东+山西+陕西+四川+贵州+广西壮族自治区+海南
商务:岚岚
联系电话:15335268233(微信同号)
地区:广东+安徽+云南+新疆维吾尔自治区+西藏自治区+青海+甘肃+宁夏+内蒙古自治区+香港+澳门+台湾+海外
商务:依依
联系电话:15335278233(微信同号)


苯硼酸修饰透明质酸(Phenylboronic Acid Modified Hyaluronic acid,HA-PBA),是在HA分子上引入苯硼酸(Phenylboronic Acid,PBA)基团而得到的一种新型生物材料。HA-PBA继承了HA良好的生物相容性,引入的苯硼酸基团能够与含有顺式邻二羟基或间二羟基结构的分子形成动态硼酸酯键,赋予材料独特的性能,如自愈合、可注射性,以及对pH、ROS、葡萄糖环境的响应性。
单宁酸(TA,Tannic Acid)为植物来源的天然多酚化合物,分子结构中富含邻苯二酚结构,可与HA-PBA通过硼酸酯键实现高效分子间交联,同时为产品赋予优异的抗菌、抗炎及抗氧化生物特性。
EFL-HA-PBA002产品整合HA-PBA、TA双组分优势,兼具环境响应性(pH、ROS、葡萄糖)与多重生物活性(抗菌、抗炎、抗氧化),使其在组织再生、伤口敷料、响应释药等领域有广阔的应用前景。

组织再生、伤口敷料、响应释药等。
干态套装:室温,3个月;4℃,12个月;-20℃,18个月。

图1. 合成原理示意图及核磁氢谱

图2. 黏度(剪切速率:10s-1,25℃)

图3. HA-PBA+TA动态水凝胶成胶及响应性原理示意图

图4. 基于苯硼酸酯的药物负载及响应性释放原理示意图

图5. 生物相容性(A,B,C,D)浸提液孵育HUVEC细胞第1天的明场图像;(D)CCK-8增殖实验检测细胞活性
图6. 4/6/8% HA-PBA+0.3% TA水凝胶对大肠杆菌和金黄色葡萄球菌的抑菌效果